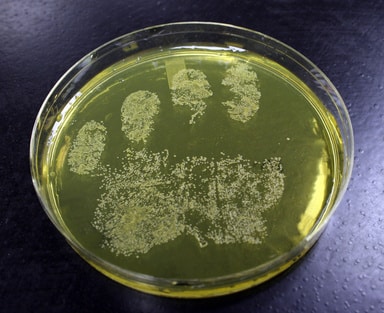

Une étude indienne parue dans le Journal of Infection Prevention démontre que 71% des téléphones portables des soignants sont porteurs de bactéries, dont 29% sont pathogènes.
Afin de mener à bien cette étude, un prélèvement bactériologique était réalisé sur chaque téléphone, puis mis en culture. Seuls 5% des prélèvements n’ont pas montré de prolifération bactérienne. Parmis les germes identifiés, les auteurs ont retrouvé le redouté staphylocoque aureus méti résistant, ainsi que Klebsiella pneumoniae et Escherichia coli.
Seuls 12% des professionnels de santé testés utilisaient une solution désinfectante pour nettoyer leur téléphone portable.
Rédaction ActuSoins

Vous devez être connecté pour poster un commentaire.